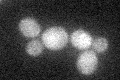
YPR078C
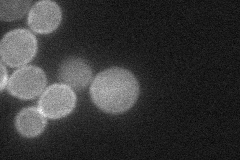
YPR078C
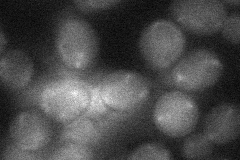
YPR078C
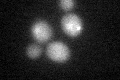
YPR078C

View description
Putative protein of unknown function; possible role in DNA metabolism and/or in genome stability; expression is heat-inducible
Localization:
Intensity:
Fold change:
Significance:
-
C’ GFP library in SD
below threshold17.04 -
N' NOP1pr-GFP in SD

cell periphery65.852 -
N' TEF2pr-mCherry in SD
cell periphery,punctate28.1864 -
N' NATIVEpr-GFP in SD

below threshold18.4091 -
N' TEF2pr-VC and Cyto-VN in SD
below threshold26.5695 -
C’ GFP library in SD+DTT
cytosol16.720.98No -
C’ GFP library in SD+H2O2

cytosol17.21No -
C’ GFP library in Starvation Media

cytosol26.561.55No -
C’ GFP library on the background of Pup2-DaMP

below threshold -
C’ GFP library on the background of CCT mutant

below threshold17.24911.0116No
